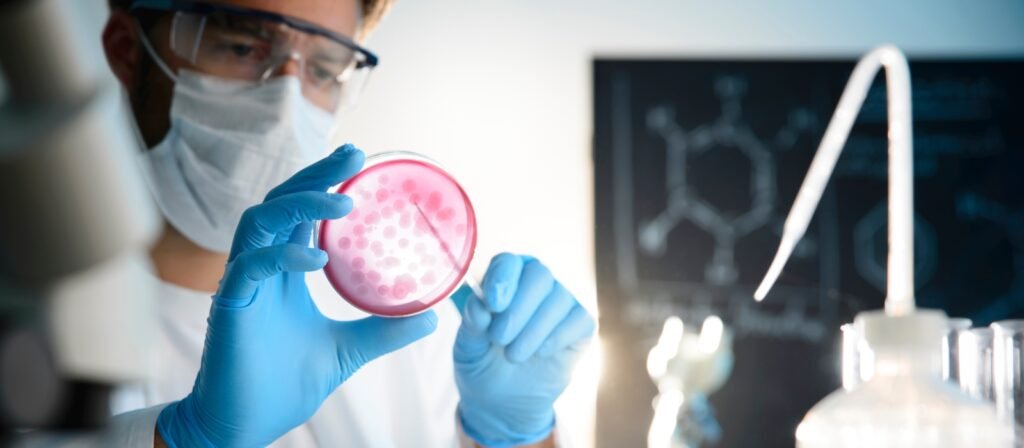

Checklist de Verificação Diária para Equipamentos de Laboratório
Manter o controle e a confiabilidade dos processos laboratoriais depende, em grande parte, da verificação diária para equipamentos de laboratório. Apesar de parecer uma tarefa rotineira e simples, negligenciar essas checagens pode levar a desvios analíticos, falhas operacionais e até riscos à segurança dos profissionais.
Um estudo publicado pela American Laboratory Journal indicou que 27% das falhas em análises laboratoriais estão associadas ao uso inadequado ou à má conservação de equipamentos. Isso reforça a importância de práticas sistematizadas de verificação para garantir a confiabilidade dos resultados, o bom funcionamento dos instrumentos e a conformidade com normas como ISO/IEC 17025, ANVISA e Boas Práticas de Laboratório (BPL).
Neste artigo, você encontrará um guia prático e completo sobre como estruturar um checklist eficiente de verificação diária, quais equipamentos devem ser monitorados e quais são os principais pontos de atenção.
Por que a Verificação Diária para Equipamentos de Laboratório é tão importante?
Equipamentos calibrados e em pleno funcionamento são essenciais para garantir a rastreabilidade, precisão e repetibilidade dos dados. A verificação diária para equipamentos de laboratório atua como uma barreira preventiva, identificando alterações antes que elas impactem negativamente nos resultados analíticos.
Além disso, seguir um checklist diário reduz paradas inesperadas, otimiza a vida útil dos equipamentos e demonstra conformidade com auditorias e inspeções regulatórias.

Equipamentos que devem passar por verificação diária
Quando se trata de manter a precisão das análises e garantir a rastreabilidade dos resultados, a verificação diária para equipamentos de laboratório não é apenas recomendável — é essencial. Alguns instrumentos, pela natureza crítica de suas funções, devem ser checados todos os dias antes do início das atividades. Esse cuidado diário reduz drasticamente o risco de falhas técnicas e evita prejuízos causados por leituras imprecisas ou desvios operacionais.
As balanças analíticas, por exemplo, são extremamente sensíveis a vibrações, temperatura e até correntes de ar. Por isso, é importante conferir diariamente se o nivelamento está correto, se há presença da bolha de ar no centro e se os pesos-padrão indicam leituras dentro da faixa aceitável.
Já em equipamentos térmicos como estufas, incubadoras e banhos-maria, a temperatura é um parâmetro que precisa ser verificado com rigor. Oscilações térmicas não só comprometem a integridade das amostras, como podem afetar reações químicas, culturas microbiológicas e a reprodutibilidade dos resultados. Por isso, recomenda-se comparar a temperatura registrada com um termômetro de referência e observar o tempo de estabilização do equipamento.
Outro item que merece atenção especial é o espectrofotômetro, presente em praticamente todos os tipos de laboratórios, desde clínicos até industriais. Uma leitura incorreta pode ter origem em cubetas mal posicionadas, sujeira na lente ou falha no sistema óptico. Por isso, durante a verificação diária, é importante validar a leitura em branco, inspecionar a limpeza do compartimento de amostras e garantir que o comprimento de onda esteja calibrado conforme o protocolo.
No caso das capelas de fluxo laminar e cabines de segurança biológica, que são cruciais para proteger tanto o operador quanto a amostra de contaminações, a verificação diária inclui observar se o fluxo de ar está constante, se há obstruções nos filtros e se o alarme e os sensores de segurança funcionam corretamente.
Embora todos os equipamentos laboratoriais mereçam atenção, alguns exigem checagens mais rigorosas diariamente. Veja abaixo os principais:
1. Balanças analíticas e semi-analíticas
-
Verificar nivelamento e bolha;
-
Realizar teste com pesos-padrão;
-
Confirmar a calibração interna ou registrar necessidade de calibração externa.
2. Estufas e incubadoras
-
Checar temperatura real vs. programada;
-
Observar o funcionamento dos sensores;
-
Inspecionar ventilação e ausência de resíduos.
3. Banhos-maria e termocicladores
-
Confirmar temperatura com termômetro de referência;
-
Verificar nível de água;
-
Observar o tempo de resposta térmica.
4. Espectrofotômetros
-
Validar luz de referência;
-
Checar leitura em branco;
-
Confirmar limpeza das cubetas e do compartimento óptico.
5. Capelas de fluxo laminar e cabines de segurança
-
Verificar filtros HEPA;
-
Testar sistema de alarme e sensores de segurança.
6. Autoclaves
-
Conferir registros de ciclos anteriores;
-
Inspecionar sensores de temperatura e pressão.
Estrutura recomendada para o checklist de verificação diária
Para que a verificação diária para equipamentos de laboratório seja eficaz, o checklist deve ser estruturado de forma clara, objetiva e adaptável à realidade do seu ambiente laboratorial.
1. Identificação do equipamento
Inclua nome, número de patrimônio, fabricante, modelo e local de uso.
2. Data e horário da verificação
A rastreabilidade das informações depende da precisão temporal. Checagens devem ser registradas no início do expediente.
3. Responsável pela verificação
Inclua nome completo, cargo e assinatura eletrônica ou manual do colaborador.
4. Itens a serem verificados
Liste os parâmetros específicos de cada equipamento. Exemplo:
-
Temperatura;
-
Calibração;
-
Condição física (limpeza, desgaste, integridade);
-
Alarmes e sensores;
-
Sinais de falhas ou comportamentos anormais.
5. Observações adicionais
Espaço livre para o colaborador relatar ocorrências não previstas ou observações relevantes.
6. Ações corretivas
Caso algum item esteja fora dos padrões, documente imediatamente a ação tomada: isolamento do equipamento, solicitação de manutenção, etc.
Frequência e responsabilidades
A verificação diária para equipamentos de laboratório deve ser realizada por analistas, técnicos ou responsáveis pelo controle de qualidade. Em laboratórios com grande fluxo de análises, recomenda-se realizar duas verificações: uma na abertura e outra antes do encerramento das atividades.
É responsabilidade da liderança garantir que todos os envolvidos estejam treinados e conscientes da importância dessa rotina. Checklists podem ser aplicados via formulários físicos, planilhas ou sistemas integrados de gestão da qualidade (LIMS, por exemplo).
Benefícios da verificação diária no desempenho analítico
A adoção consistente da verificação diária para equipamentos de laboratório traz vantagens operacionais e estratégicas:
-
🔍 Redução de falhas em análises: evita o retrabalho por equipamentos descalibrados ou mal conservados;
-
🧾 Apoio em auditorias: registros de verificação diária mostram controle de processos e rastreabilidade;
-
⚙️ Aumento da vida útil dos equipamentos: checagens simples evitam desgaste prematuro;
-
🧬 Melhoria contínua na qualidade dos dados: quando o equipamento está estável, a análise é confiável;
-
💰 Redução de custos com manutenção corretiva e perdas de amostras.
Segundo dados da Association of Analytical Communities (AOAC), laboratórios que implementam checklists operacionais reduzem em até 35% as ocorrências de falhas críticas em equipamentos, aumentando a confiabilidade dos processos e o desempenho em auditorias externas.
Integração com normas e certificações
A verificação diária para equipamentos de laboratório está alinhada com os requisitos das principais normas e regulamentações nacionais e internacionais:
-
ISO/IEC 17025: exige evidências de que os equipamentos estejam sob controle metrológico contínuo;
-
Boas Práticas de Laboratório (BPL): recomendam registros diários de inspeção e manutenção preventiva;
-
ANVISA (RDC 665/2022): reforça o uso de procedimentos validados e rastreáveis em equipamentos críticos;
-
INMETRO: emite certificados de calibração que devem ser mantidos atualizados, com registros de uso diário.
Ou seja, o checklist não é apenas uma ferramenta de organização: ele é parte essencial da qualidade regulatória e da reputação técnica do laboratório.
Dicas para implementar a verificação diária com eficiência
-
✅ Padronize o checklist por tipo de equipamento;
-
✅ Digitalize os registros sempre que possível;
-
✅ Treine os usuários com exemplos práticos de falhas reais;
-
✅ Inclua auditorias internas periódicas para revisar os registros;
-
✅ Incentive o reporte proativo de não conformidades.
Conclusão
A verificação diária para equipamentos de laboratório é um pilar fundamental da gestão da qualidade, da segurança operacional e da excelência analítica. Ela permite identificar problemas antes que se tornem críticos, evita retrabalho, aumenta a vida útil dos equipamentos e garante que os dados produzidos sejam confiáveis e rastreáveis.
Implementar um checklist bem estruturado não é um custo — é um investimento que se traduz em eficiência, credibilidade e conformidade regulatória.
Em tempos em que cada resultado precisa ser tecnicamente defensável, deixar de verificar seus equipamentos é, sem dúvida, um risco que nenhum laboratório pode correr. Gostou do nosso conteúdo? Compartilhe!

A Splabor é uma empresa líder no ramo de fabricação de equipamentos para laboratório, especializada em oferecer uma ampla variedade de equipamentos para laboratórios, materiais e produtos para laboratório de alta qualidade.